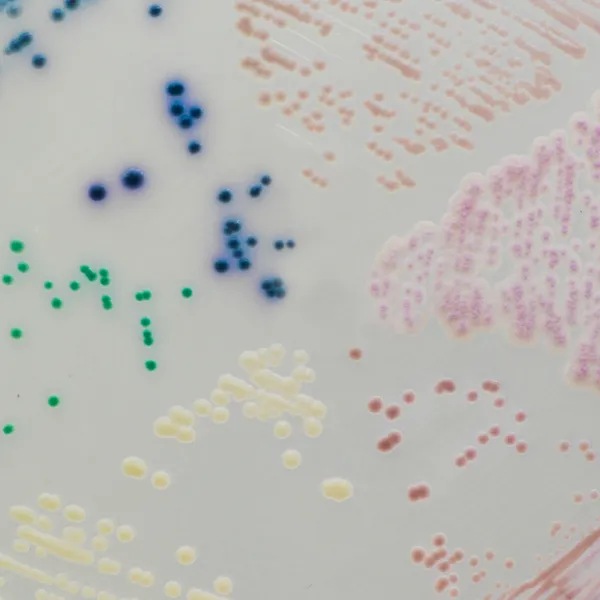
CHROMagar™ Candida

Hình thái khuẩn lạc

Candida albicans
xanh lá cây

Candida glabrata
màu hoa cà

Candida tropicalis
xanh kim loại

Candida krusei
hồng, mờ
Hiệu năng
Hiệu năng
Có lẽ do tiến bộ trong điều trị y tế với việc giảm kháng cự của bệnh nhân và tăng số lượng người dễ nhiễm, tỷ lệ nhiễm Candida trong máu đã tăng trong những năm 1990 nhưng đã ổn định trong những năm gần đây. Thường thấy hơn, các loài Candida liên quan đến nhiễm khuẩn nông ở miệng và đường niệu sinh dục, đặc biệt ở những người suy giảm miễn dịch như người già và nạn nhân AIDS. “Chẩn đoán sớm rất cần thiết để quản lý hiệu quả sớm bệnh nhân.” (Hướng dẫn của WHO về Quy trình Hoạt động Tiêu chuẩn để Chẩn đoán Phòng thí nghiệm các Nhiễm trùng Cơ hội HIV). Mặc dù C. albicans vẫn là loài chính gây ra, nhưng các loài khác như C. tropicalis,
C. krusei hoặc C. glabrata đã tăng tỉ lệ tỷ lệ do các tác nhân kháng nấm mới hoạt động rất hiệu quả chống lại C. albicans. Điều này cho thấy tầm quan trọng của việc phát hiện chính xác để lựa chọn liệu pháp kháng nấm phù hợp.
Mục đích sử dụng:
CHROMagar™ Candida là môi trường nuôi cấy chromogen chọn lọc dành để phát hiện định tính trực tiếp, phân biệt và nhận dạng sơ bộ các loài Candida. Xét nghiệm được thực hiện với các mẫu gạc từ da, họng, tai và mẫu âm đạo cũng như mẫu đờm, nước tiểu và phân, song song với nuôi cấy trên thạch Sabouraud, để hỗ trợ chẩn đoán Candidiasis. Kết quả có thể được diễn giải sau 20-48 giờ ủ hiếu khí ở 35-37 °C.
Cần thực hiện thêm xét nghiệm vi sinh hoặc định kiểu dịch tễ học. Việc thiếu tăng trưởng hay không có khuẩn lạc trên CHROMagar™ Candida không loại trừ sự hiện diện của Candida. CHROMagar™ Candida không nhằm chẩn đoán nhiễm trùng hay hướng dẫn hoặc theo dõi điều trị nhiễm trùng.
1. Độ tương phản cao: Màu sắc khuẩn lạc đậm giúp phân biệt loài và vi khuẩn hỗn hợp.

2. Nhanh: Ủ 20 - 48 giờ.
5. Giảm khối lượng công việc: Với môi trường truyền thống như thạch Sabouraud, việc nhận dạng vi hệ hỗn hợp là khó khăn, trong khi CHROMagar™ Candida, chỉ qua màu sắc khuẩn lạc, sẽ ngay lập tức phân biệt các loài Candida khác nhau và giúp xác định vị trí các khuẩn lạc trong các khuẩn lạc hỗn hợp.
3. Tầm nhìn toàn cảnh: Tầm nhìn toàn cảnh về hỗn hợp dân số Candida với khả năng phát hiện các loài chính nhưng cũng sự hiện diện của các quần thể phụ.
Thành phần

Tài liệu kỹ thuật
Công bố khoa học
2023
Thymoquinone Antifungal Activity against Candida glabrata Oral Isolates from Patients in Intensive Care Units—An In Vitro Study
? Publication2023
Effect of Antimicrobial Photodynamic Therapy, using Toluidine blue ondual-species biofilms of Candida albicans and Candida krusei
? Publication2023
Fungal Spectrum and Susceptibility Against Nine Antifungal Agents in 525 Deep Fungal Infected Cases
? Publication2023
Identification of Candida Species Associated with Blood Infection by Multiplex PCR and Phenotypic Characteristics
? Publication2023
Usefulness of Chromogenic Media with Fluconazole Supplementation for Presumptive Identification of Candida auris
? Publication2023
Effects of Candidalysin Derived from Candida albicans on the Expression of Pro-Inflammatory Mediators in Human Gingival Fibroblasts
? Publication2022
Candida guilliermondii as an agent of postpartum subacute mastitis in Rio de Janeiro, Brazil: Case report
? Publication2018
Assessment of Identification Methods for Candida auris in Microbiology Laboratories in British Columbia
? Publication2017
Prevalence of Candiduria in Diabetic Patients attending the Bafoussam Regional Hospital (West Cameroon) and Antifungal Susceptibility of the Isolates
? Publication2017
An in vitro study of isolation of candidal strains in oral squamous cell carcinoma patients undergoing radiation therapy and quantitative analysis of the various strains using CHROMagar
? Publication2017
Evaluation of CHROMagar Candida in the rapid identification of medically important species of Candida
? Publication2017
Comparison of CHROMagar, polymerase chain reaction-restriction fragment length polymorphism and polymerase chain reaction-fragment size for the identification of Candida species
? Publication2016
CHROMagar as a primary isolation medium for rapid identification of Candida and its role in mixed Candida infection in sputum samples
? Publication2016
Evaluation of Diagnostic Efficacy of CHROMagar Candida for Differentiation and Identification of Common Candida Species
? Publication2015
Colonization and antifungals susceptibility patterns of Candida species isolated from hospitalized patients in ICUs and NICUs
? Publication2015
Utility of Chromagar Medium for Antifungal Susceptibility Testing of Candida Species Against Fluconazole and Voriconazole in Resource Constrained Settings
? Publication2015
Routine identification and mixed species detection in 6,192 clinical yeast isolates
? Publication2014
Speciation of Candida species isolated from clinical specimens by using Chromagar and conventional methods
? Publication2013
Epidemiology, Antifungal Susceptibility and Pathogenicity of Candida africana Isolates from the United Kingdom
? Publication2013
Salivary Candida species carriage patterns and their relation to caries experience among Yemeni children
? Publication2013
Evaluation of chromogenic media and seminested PCR in the identification of Candida species
? Publication2012
Identification of Candida Species Screened from Catheter Using Patients with PCR-RFLP Method
? Publication2011
Comparación entre métodos convencionales, ChromAgar Candida® y el método de la PCR para la identificación de especies de Candida en aislamientos clínicos
? Publication2011
Characteristics of growth of yeasts and yeast-like fungi on chromogenic medium CHROMagar™ Candida (GRASO)
? Publication2011
Do incubation temperature, incubation time and carbon dioxide affect the chromogenic properties of CHROMagar?
? Publication2010
Evaluation of four chromogenic media for presumptive identification and differentiation of yeasts
? Publication2010
Use of CHROMagar Candida for the presumptive identification of Candida species directly from clinical specimens in resource-limited settings
? Publication2010
Comparacion entre metodos convencionales, CHROMagar Candida y el método de la PCR para la idenfificacion de especies de Candida en aislamientos clinicos
? Publication2007
Efficacy of Chromogenic Candida Agar for isolation and presumptive identification of pathogenic yeast species
? Publication2007
Sensibilidad a fluoconazol y voriconazol de aislamientos de Candida spp. obtenidos de mucosa oral de patientes con sida
? Publication2006
The evaluation of CHROMagar Candida as an isolation medium for identification of Candida species isolated from different clinical specimens
? Publication2005
Evaluación del medio cromógeno CHROMagar CandidaTM para la identificación de levaduras de interés médico
? Publication2004
Evaluation of biochemical and serological methods to identify and clustering yeast cells of oral Candida species by CHROMagar test SDS-page and Elisa
? Publication2003
Detection of fluconazole-resistant isolates of Candida glabrata Detection of fluconazole-resistant isolates of Candida glabrata by using an agar screen assay
? Publication2002
Replacement of Candida albicans with Candida dubliniensis in human immunodeficiency virus-infected patients with oropharyngeal candidiasis treated with fluconazole
? Publication2002
Case report : Candida glabrata oropharyngeal candidiasis in patients receiving radiation treatment for head and neck cancer
? Publication2002
Persistence of Pigment Production by yeast isolates grown on CHROMagar Candida medium
? Publication2001
A Comparison of Methods for Yeast Identification Including CHROMagar Candida, Vitek System YBC and a Traditional Biochemical Method
? Publication1999
Simple, reliable, and cost-effective yeast identification scheme for the clinical laboratory
? Publication1999
Evaluation of CHROMagar Candida for rapid screening of clinical specimens for Candida species
? Publication1998
Evaluation of CHROMagar Candida for Presumptive Identification of Clinically Important Candida Species
? Publication1998
Candida species from genital sites: their identification and susceptibility to fluconazole
? Publication1998
Diferenciacion e identificacion presuntiva rapida de levaduras con el medio CHROMagar Candida
? Publication1998
An evaluation of the cost-effectiveness of using CHROMagar for yeast identification in a routine microbiology laboratory
? Publication1998
Detection of Candida dubliniensis in oropharyngeal samples from human immunodeficiency virus-infected patients in North America by primary CHROMagar Candida screening and susceptibility testing of isolates
? Publication1998
Identificacion de levaduras de interes clinico en el medio de cultivo CHROMagar Candida
? Publication1997
Molecular and phenotypic analysis of Candida dubliniensis : a recently identified species linked with oral candidosis in HIV-infected and AIDS patients
? Publication1997
Use of specialised isolation media for recognition and identification of Candida dubliniensis isolates from HIV-infected patients
? Publication1996
Application of CHROMagar Candida for rapid screening of clinical specimens for Candida albicans, Candida tropicalis, Candida krusei, and Candida (Torulopsis) glabrata
? Publication1996
Routine use of CHROMagar Candida medium for presumptive identification of Candida yeast species and detection of mixed fungal populations
? Publication1994
CHROMagar Candida, a new differential isolation medium for the presumptive identification of clinically important Candida species
? Publication

Xem thêm